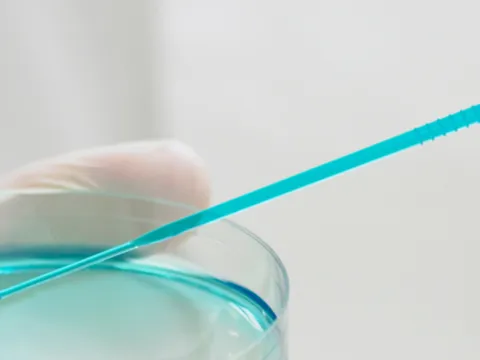

Pasar al contenido principal
La resistencia a los antimicrobianos pone en riesgo a los tratamientos de enfermedades infecciosas y no transmisibles
La resistencia a los antibióticos es una amenaza importante para la salud mundial que impacta a las ENT